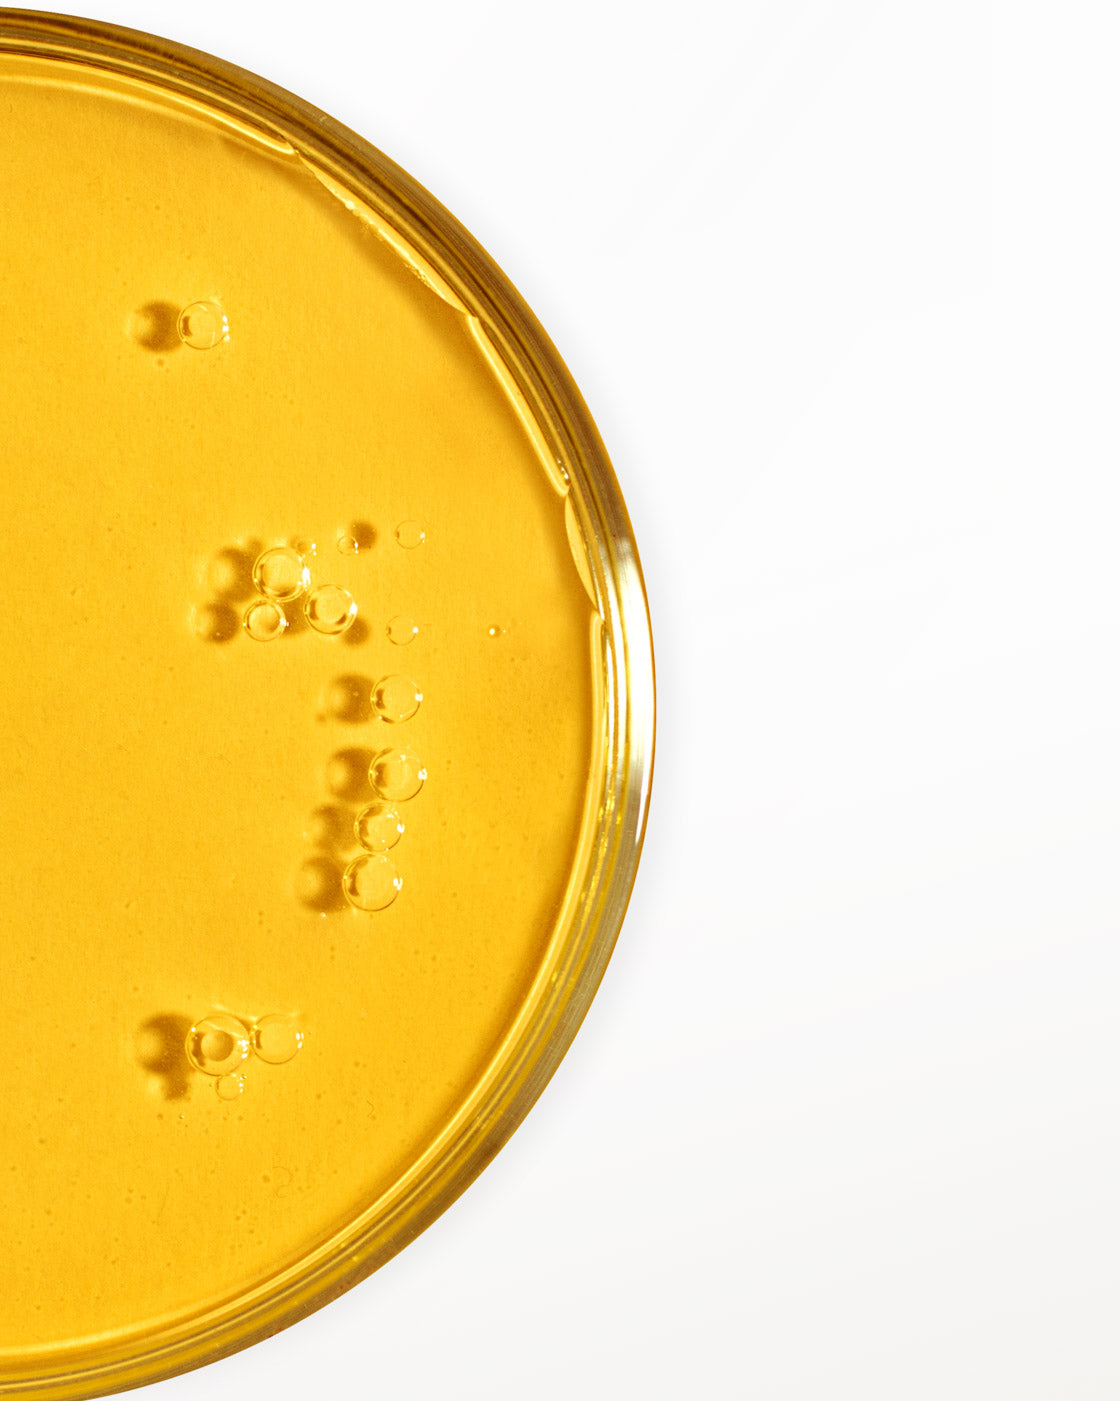

7-Piece Deluxe Face & Neck Skincare System
7-Piece Deluxe Face & Neck Skincare System
Our deluxe system is formulated with best-in-class ingredients to hydrate and help visibly firm and smooth skin as it evens the appearance of skin tone, gradually fades the look of dark spots and discoloration and minimizes the look of fine lines and wrinkles.





- Conveniently ships to your door every three months.
- No commitment. Cancel anytime. Need to postpone? No Problem.
- Save on every delivery. Manage your subscription online and save even more when you add additional products.
- FREE SHIPPING ON TODAY’S ORDER
How it works:
You save 66% on your first shipment by subscribing to auto-delivery. You can change the frequency, postpone or cancel anytime. Approximately one month after your first order is shipped, and then approximately every three months thereafter, you will be sent a full size supply. Each shipment will be charged to the payment method you provide today, in three monthly payments of $49.95 plus $3.99 for shipping and handling charges.

THE SYSTEM

REAL RESULTS
in 8 weeks*
REAL
RESULTS
in 8 weeks*
EYES LOOK LIFTED
100%
of women said they feel more confident
about the overall appearance of their skin.*
SKIN LOOKS SMOOTHER
97%
of women said they feel
confident wearing less makeup.*
*Results based on a 8 week user perception study.
Individual results will vary.
7-Piece Deluxe Face & Neck Skincare System INCLUDES
Youth Activating Melon Serum Advanced Formula
Youth Activating Melon Serum Advanced Formula

Anti-Aging Day Crème Broad Spectrum SPF 30 Sunscreen
Anti-Aging Day Crème Broad Spectrum SPF 30 Sunscreen

Age Recovery Night Crème with Melon Extract and Retinol
Age Recovery Night Crème with Melon Extract and Retinol

LIFTING EYE CRÈME Advanced Formula
LIFTING EYE CRÈME Advanced Formula

Skin Softening Gentle Cleanser
Skin Softening Gentle Cleanser

Skin Brightening Décolleté and Neck Treatment Broad Spectrum SPF 15 SUNSCREEN
Skin Brightening Décolleté and Neck Treatment Broad Spectrum SPF 15 SUNSCREEN

GLOWING SERUM
GLOWING SERUM